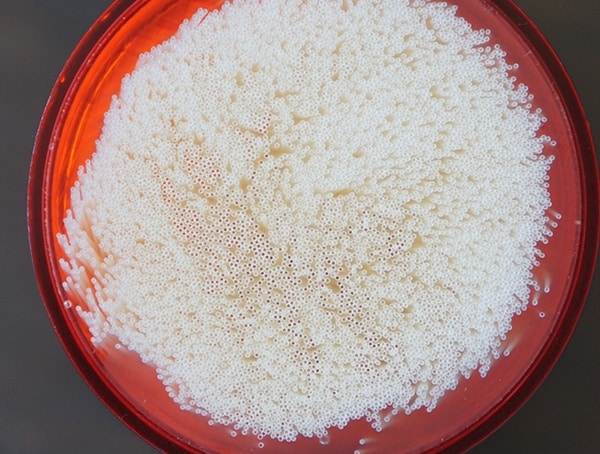
Msr Guardian Purifier Hollow Fiber Cartridge To Treat Water

When it comes to the MSR Guardian Purifier, this essential piece of outdoor gear is truly the crème de la crème. Yes, the price tag may be slightly intimidating for some, but when it comes to the MSR Guardian you really do get what you pay for.
As someone who invests in the best gear out possible, I can assure you that the MSR Guardian Purifier is worth every single penny and offers a ton of value for both beginners and experienced outdoorsmen alike. Now, I’ve had the opportunity to field test all sorts of water filters over the years, yet, none have left me as impressed as this one has.
Tested to military standards (NSF protocol P248), the MSR Guardian removes everything from viruses to bacteria, protozoa and sediment from “worst case” water. Thanks to a hollow fiber filter, there’s no need for chemicals, bulbs, batteries or waiting around in order to get viral protection from contaminated water sources.
With a 0.02 microns filter pore size, this purifier treats water exceptionally well, yet it does so in a manner that is extremely efficient. With an easy 4-pound pump force, each stroke produces 2.5 liters of clean, drinkable water per minute.
Before I dive into all of the details too quickly, go ahead and explore the unboxing first. Below, you’ll find my in-depth MSR Guardian Purifier review alongside field-testing and my impressions.
Quick Highlights:

- Meets NSF protocol P248, military testing standard
- Removes viruses, bacteria, protozoa, and sediment from “worst-case” water conditions
- 4 pound pump force outputs a rapid 2.5 liters per minute
- Viral protection without the need for chemicals, bulbs, batteries, or waiting.
- Pump self-cleans on every stroke using 10% of water
- Hollow fiber cartridge treats up to 10,000+ liters
- Withstands heavy use, freezing, certain drops, and harsh environments.
- 0.02 microns filter pore size
- Field maintainable
- Water bottle adapter
- Available replacement MSR cartridges
- Weights 1lbs 1oz
- BPA free
- Cartridge life indicator
MSR Guardian Purifier Review

While pumping, the MSR Guardian features a far more natural range of motion than the kind that I’ve experienced with other pump-style water filters. The handle is nice and long, making it easy to grab onto, while the base of the purifier is wide enough to let you grab on with a second hand. In terms of comfort and ease of use, the purifier isn’t awkward to hold or unstable to operate at all, in reality, it’s almost perfect.
In terms of operation, what I’ve also come to appreciate is the pump’s self-cleaning nature. Instead of having to back flush the pump, it automatically does all the cleaning for you by utilizing 10% of the water from every stroke.
Of course, MSR didn’t just stop there, instead, they made the Guardian purifier even easier to maintain. In just a few moments you can field service the entire purifier without needing any spare tools. Best of all, MSR replacement cartridges can be installed in pretty much the blink of an eye.








For the input water hose, MSR has included a foam end piece that floats on the top of the water to reduce sediment intake. While I personally like how MSR went about designing this, what I like even more is the hose length; it’s generous! I can literally throw this thing into any water source without having to risk falling in myself. On other water filters out there you really have to be on top of the water source in order to collect it.
When it comes to suction, the MSR Guardian is a master at sucking up water from even the shallowest of sources. The design profile really lets you extract as much water as possible regardless of the low depth.
For outputting the clean, treated water, the MSR Guardian has two solid options. The first is to use its water bottle adapter which is built onto the bottom of the purifier itself. To eliminate cross-contamination, there’s a red cap you can twist on or off to access this area. Should you not have a bottle handy, you can also hook up a hose to the barb in the middle of the purifier. For filling up virtually any container or bladder, the process is pain-free.











While the design is primarily plastic, you might be glad to know that MSR has made the Guardian BPA free. Surprisingly, this purifier is as tough as nails and can really take a beating. Not only will it withstand certain drops and heavy use, but it also can handle freezing and harsh conditions like a champ.
At 1lbs 1oz some may consider this be on the heavier side, yet, it actually weighs close to the Katadyn pocket. For me personally, I don’t mind the weight in exchange for a piece of outdoor gear that I trust, not to mention, really enjoy using.
When stored in the mesh zipper bag with the hose coiled around the base, the MSR Guardian has a rather compact profile. Sure, it takes up some space in my pack but it’s a reasonably small amount of space. With that said, when it comes to treating water in the wild, the MSR Guardian is one of my all-time favorite pieces of gear.


